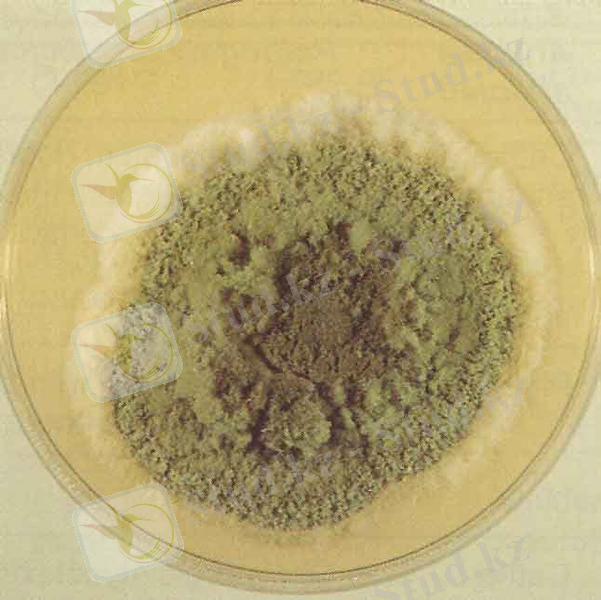
C:\Users\Айгуль\Desktop\diagn5_l.jpg

Аспергиллотоксикозға микробиологиялық бақылау: афлатоксиндер мен охратоксиндердің диагностикасы және алдын алу


Қазақстан Республикасы Ауыл Шаруашылық министрлігі
ҚАЗАҚ ҰЛТТЫҚ АГРАРЛЫҚ УНИВЕРСИТЕТІ
Ветеринария факультеті
Биологиялық қауіпсіздік кафедрасы
РЕФЕРАТ
Тақырыбы: Аспергиллотоксикозға микробиологиялық бақылау жүргізу
Орындаған: Әбіл Ұлжан
Тексерген: Мықтыбаева Рая
АЛМАТЫ 2015 ж
Жоспар
I. Кіріспе
II. Негізгі бөлім
1. Аспергиллотоксикоз қоздырғыштарына жалпы сипаттама және культурасын өлтіру және зардаптылығы
2. Афлатоксикозға және охратоксикозға сипаттама
3. Афлатоксикоздың және охратоксикоздың симптомдары және патогенезі
4. Афлатоксикоздың және охратоксикоздың диагноз қою, емдеу және алдын алу
III. Қорытынды
IV. Пайдаланған әдебиеттер
I Кіріспе
Ауыл шаруашылығы жануарларының улы микроскопиялық саңырауқұлақтармен зақымдалған жем - шөппен азықтануы себепті пайда болатын ауру түрлерін микотоксикоздар қатарына жатқызады. Осы аурулар тобына клавицепстоксикоз, эрготизм, жылқының дендродохиотоксикозы, стахиоботриотоксикоз, фузариотоксикоз, аспергиллотоксикоз, көгеріп кеткен өсімдік токсикоздары жатады. Митоксикоздарды қоздыратын саңырауқұлақтар көбіне жетілмегендер қатарына (fungi imferfecti) және қалталылар қатарына (Аscomycetes) жатқызылады.
II Негізгі бөлім
- Аспергиллотоксикоз қоздырғыштарына жалпы сипаттамажәне культурасын өлтіру және зардаптылығы. Аспергиллотоксикоз - Aspergillus туысы саңырауқұлақтарымен зарарланған азық жегеннен пайда болатын малдардың ауруы. Азық көбіне A. fumigatus, A. flavus, A. niger, A. clavatus, A. wentii, A. Chevalieri грибтерімен зарарланады. Aspergillus түрінің саңырауқұлақтары аскомицеттер класына, Plectoascales қатарына, Aspergillaceae тұқымдасына жатады.
Саңырауқұлақтардың буынтақталған мицелийлері және бір клеткалы кондиеносцестері болады, оның томпақша келген жоғары жағында споралардың - конидийлердің ( грекше - шаң) тізбектері таралады. Аспергиллдерді микроскоппен зерттегенде оның өсіп - өнетін бөлігінде аққан су тамшылары сияқты заттарда көруге болды, оның «су сепкіш зең саңырауқұлағы» деп аталатыны да осыдан. Мицелийлер мен конидиеносецтер түссіз болады, ал кондийлердің көптеген түрі жасыл және қара түске боялған.

Грибтер рН 5, 0 - 6, 0 23 - 26 °С температурада, Чапек ортасында жақсы өседі. Ал грибі 37 °С - де және одан жоғары температурада өсіруге болады.
Аспергиллдер табиғи сабстраттарда жемде, жем - шөпте, сондай - ақ синтетикалық орталарда улы өнімдер түзеді. Аспергиллдердің отыздан астам түрінің у шығару қабілеті бар. Осы грибтің 14 түрі токсині болады.
2 - сурет. Аспергилдердің көрінісі
В 1 , В 2 фракцияларының уы өте күшті, өйткені бұлардың концерогенді қасиеті бар. Бұл токсиндер афлатоксиндер деп аталады, мұның себебі, олар алғаш рет Aspergillus грибімен зақымдалған арахис ұнының экстрактысынан алынды. Химиялық құрамы жағынан афлатоксин кумариндер тобына жатады. А. Fumigatus грибі биологиялық жағынан активті заттар түзе алады. Бұл саңырауқұлақтың токсикалық меттаболиттерді: фумагиллинді болып отыр. Олардың бәрі термостабильді, токсикоз қоздыра алады, гемолитикалық және антигендік қасиеттері болады.
- Афлатоксикозға және охратоксикозға сипаттама. Афлатокикоздар- құрамында токсин метаболиттер, афлатоксиндер (As-pergillus flavus және Aspergillus parasiticus) бар, тамақ жегенде пайда болатын ауру. Афлатоксиндер - аспергилл саңырауқұлақтарының екінші метаболиттері.
«Афлатоксин» - A(spergillus) Fla(vus) toxinus деген сөздерден шыққан. Олар 1960 жылы Ұлыбританияда ашылған. Олар өсімдікті тағамдардан, әсіресе, дәнді дақылдардан кең таралады, олардың әсер ету басы- афлатоксин B1, B2, B2a; G1, G2, G2a; M1, M2; Және де олар жер жаңғақта, сәбізде, асбұршақта, какаода, етте, сүтте және сырда табылған. Афлатоксиндер термиялық қайта өндіруде бұзылмайды. Олар өте улы болып келеді. Мысалы, жануарлардың өткір улануы В тобындағы афлатоксинмен шақырылған. Өткір улану қозғалыстың бұзылысымен, бауырдың зақымдалуымен (цирроз, некроз алғашқы рактың дамуымен), тырысқақпен, геморрагиямен, ісіктермен, және де асқазан - ішек жолдарының қызметінің бұзылысымен анықталады.
Бұлар үй құстарының ауруының этиологиясы, Ұлыбритания, Кения, Уганда және басқа елдерде етек алғанда, 1960 - жылдардан өздеріне ерекше көңіл аударды.
Афлотоксиндер тұқымдасы 18 қосылысты ( 4 негізгі және 14 негізгі топтар метаболиттері) біріктіреді. Бұлардың бәрі фурокумариндер. Афлотоксиндер ерітінділері қараңғы және салқын жерде жылдам сақталады. Аммиак не натрий гипохлоридімен өндегенде олардың активтігі кемиді. Афлотоксиндер қосылыстарын ажырату оларға тән флуресценцияға негізделген, осының арқасында бұндай қосылыстарды аз мөлшерде (1 л сүтте 0, 002 мкг) болса да табуға мүмкіндік туады.
60 жылдардың басында зақымданған жөмшөптен дамыған микотоксикоз күркетауық, үйрек балапандары, бұзау және шошқадан табылды. Афлатоксиндер күшті гепатотропты у. Бұдан басқа олардың канцерогендік, тератогендік және мутагендік қасиеттері бар.
Аспергилл саңырауқұлақтары метаболиттерінің арасында ең токсиндісі - афлатоксин В 1 . Афлатоксиндер күшті иммунитет тежеушілер. Олар клеткалық және гумааральдық иммунитетті тежейді. Бауырды ауруға шалдықтырып, олар сонымен қатар осы органға концерогендік әсер етеді. Нуклеин қышқылдары мен белок синтезін баяулатады. Жемшөпте 0, 1 - 0, 4 мкг/кг мөлшеріндегі афлотоксин В 1 жұмыртқаның ақ және сары уызына өтеді, осының салдарынан олардың ұрықтануы кемиді. Афлатоксинді саңырауқұлақтар өсіп тұрған астық тұқымдас өсімдіктерге және жемшөптік дақылдарға микотоксин шығармайды, сондықтан афлатоксин егістікте байқалмайды.
Және де аспергилалар микотоксиндердің басқа да түрлерін өндіреді- охратоксиндер А, В, С(A. ochra-Wceus), патулин(A. terreus, A. niverus, A. candi, глиотоксин(A. giganteus, A. fumigatus), стеригматоцистин(A. versicolor, A. nidulans), треморген(A. clavatus, A. flavus, A. candidum), цитохалазминалар(A. clavatus), цитринин(A. terreus, A. niveus, A. candidum) .
Охратоксиндер структурасы бойынша изокумариндер. Алғаш Оңтүстік Африка елдерінде зең саңырауқұлағы Aspergillus ochraceus культурасынан бөлініп алынған, аты осыдан шыққан. Аспергил саңырауқұлақтары шығаратын охратоксиндер көбіне оңтүстік елдерінде, пенциллинум мен бірге - солтүстікте кездеседі. Бірақ бұл аралас микотоксикоз емес, микотоксиндардың бір түрі ғана тарататын ауру. Бірнеше А, В, С, Д, охратоксиндер белгілі. Жем - шөпке түсуші ретінде жиі кездесетін охратоксин А, сирек кездесетіні охратоксин В.
Охратоксин А түссіз, кристалды зат, суда нашар, хлороформда, этанолда, ацетонда сілті ерітінділерінде жақсы ериді.
Охратоксин В - Охратоксин А тәрізді, соған ұқсас, бірақ бұнда хлор жоқ. Охратоксин А - ға қарағанда токсиндік күші кем (50 есе) .
Охратоксиндер көбіне бүйректі ауруға шалдықтырады, дегенмен патологиялық өзгерістер ішек - қарын жолында, бауырда, лимфоидты тканьдарда дабайқалады.
Бұл ауру көбіне шошқада ( өлімі 40 - 90 % - ға жетеді), балапанда, мекиенде, күрке тауық балапандарында, сирегірек сиырда, үйрек балапандарында кездеседі. Охратоксикозға ит сезімтал. Охратоксикоз Еуропаның көптеген елдерінде, АҚШ - та, Жапогияда және дүние жүзінің басқа да аймақтарында тараған.
- Афлатоксикоздың және охратоксикоздың симптомдары және патогенезі. Жануарлардың жем - шөпке тәбеті тартпайды, қозғалыстарының реттелуі бұзылады, сіңір тартылады, бұлшық ет тырысып - түйіледі, парезге ұшырайды. Бұдан басқа геморрагия, ісіс кейде сілекей қабық сарғаюы байқалады.
Афлатоксинаға шошқа мен бұзау сезімтал келеді. Құс афлатоксикоззы дүние жүзінің барлық елдерінде кездеседі.
Сауын сиырға афлатоксиндер түскен жемшөп берілсе сүті азаяды, сүт безінің қызметі бұзылады. Тіршілік қабілеті кем әлсіз бұзау туады. Басқа малдардан афлатоксинаға қой төзімсіз келеді.
Малдың организіміне ене отырып афлотоксиндер бауырдың функционалдық қызметін бүлдіреді, кейбір ферменттердің белсенділігін төмендетеді, РНҚ - ның метобализмін өзгертеді, белоктардың синтезін бұзады, мүшелерді майлы және белоктық дистрофияға ұшыратады, гепотоцидтерді өлікттендіреді, канцерогенді, тератогенді және мутагенді әсер етеді.
Алғашқы белгілері 1-3 күннен кейін байқала бастайды. Улану жіті, жітілеу және созылмалы түрде кездеседі.
Жылқыларда аздаған қозу пайда болып, ол тежелу сатысына алмасады. Жем-шөптен қалады, шөлдейді. Ауыз қуысының кілегей қабықтары қызарады, ішектің перистальтикасы күшейеді, нәжіс кілегейлі заттармен араласады. Температура төмендейді, тамыр соғуы және тыныс алуы жиілейді, мал жатаған келеді, бұлшық еттері тартылады.
Ірі қарада алғашқы белгілер 4-6 күннен кейін пайда болады. Көз қарашығы үлкейеді, бұлшық еттері тартылады, құлақтарының ұштары, аяқтарында, бас терілерінде өліеттенулер көрінеді, жалпы әлсірейді, кілегейі қабықтар сарғаяды, тәбеті төмендейді, сілекей көп бөлінеді, жөтеледі, тремор, асқорыту және жүйке жүйесі жұмысы нашарлайды. Буаз мал іш тастайды, бұзаулардың іші өтеді, тамыр соғуы және тыныс алуы жиілейді.
Қойларда: Жалпы әлсірейді, тәбеті төмендейді, саливация, несеп бөлу жиілейді, гипотония, атония және тимпания қалыптасады, қарын ісінеді.
Шошқаларда: Жалпы қозу, атаксия, тремор, іш өту, парез секілді белгілерімен қатар, ас қорыту жолының функциясы бүлінеді, құсады, салданады, тілі, қызыл иегі, желінінің, құлағының ұштары, аяқтарының, бас терісінің кейбір бөліктері өлеттенеді.
Құстарда: Жалпы әлсірейді, тәбеті төмендейді, айдары мен сырғалығы көгереді.
Патологиялық - анатомиялық өзгерістерінде кілегейлі қабықтар катаральді түрде қабынады, асқазан мен кейбір ішектердің кілегейлі қабықтары өлеттенеді. Бауыр үлкейеді, жүректе қан ұйюлар байқалады, өкпесі қызарған әрі ісінген. Миы қанға толы, паренхимтозды мүшелерде дистрофиялық өзгерістер білінеді. Бронхтар мен бронхиолалар көбіктенген, қан аралас сұйықтыққа толы.
Аспергиллдердің токсиндері жергіілікті және жалпылама әсер етеді. Жергілікті процесс орын алғанда тері, тыныс алу органдарының кілегей қабығы және конъюнктива қабынады. Жалпылама әсер еткенде орталық жүйке жүйесінің қабыну белгілері пайда болады. Токсикалық мөлшер зат алмасуын бұзады, маңызды органдардың семіп өзгеруі кездеседі.
... жалғасы- Іс жүргізу
- Автоматтандыру, Техника
- Алғашқы әскери дайындық
- Астрономия
- Ауыл шаруашылығы
- Банк ісі
- Бизнесті бағалау
- Биология
- Бухгалтерлік іс
- Валеология
- Ветеринария
- География
- Геология, Геофизика, Геодезия
- Дін
- Ет, сүт, шарап өнімдері
- Жалпы тарих
- Жер кадастрі, Жылжымайтын мүлік
- Журналистика
- Информатика
- Кеден ісі
- Маркетинг
- Математика, Геометрия
- Медицина
- Мемлекеттік басқару
- Менеджмент
- Мұнай, Газ
- Мұрағат ісі
- Мәдениеттану
- ОБЖ (Основы безопасности жизнедеятельности)
- Педагогика
- Полиграфия
- Психология
- Салық
- Саясаттану
- Сақтандыру
- Сертификаттау, стандарттау
- Социология, Демография
- Спорт
- Статистика
- Тілтану, Филология
- Тарихи тұлғалар
- Тау-кен ісі
- Транспорт
- Туризм
- Физика
- Философия
- Халықаралық қатынастар
- Химия
- Экология, Қоршаған ортаны қорғау
- Экономика
- Экономикалық география
- Электротехника
- Қазақстан тарихы
- Қаржы
- Құрылыс
- Құқық, Криминалистика
- Әдебиет
- Өнер, музыка
- Өнеркәсіп, Өндіріс
Қазақ тілінде жазылған рефераттар, курстық жұмыстар, дипломдық жұмыстар бойынша біздің қор #1 болып табылады.



Ақпарат
Қосымша
Email: info@stud.kz